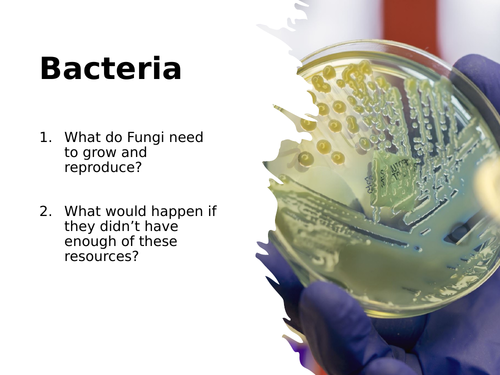
pptx, 4.23 MB

Discover the vast diversity of life on Earth with our educational unit on “Unicellular and Multicellular Organisms.” This resource is meticulously designed to guide students through the complexity and simplicity of life forms, from the tiniest bacteria to the intricacies of multicellular life.
Key Features:
Foundational Presentations: Begin with the “Kingdoms Table” to classify and differentiate between the major groups of life.
Comparative Analysis: Delve into “Unicellular vs Multicellular” organisms with a detailed examination of their structures and life processes.
Microscopic Worlds: Reveal the hidden details of “Microscopic Fungi” and their roles in ecosystems.
Bacterial Diversity: Explore the “Bacteria” presentation, which showcases the importance and variety of these microorganisms.
Eukaryotic Exploration: Gain insight into “Protocists,” the eukaryotic organisms that defy the traditional categories of plant, animal, and fungi.
Ecological Impact: Understand how “Decomposers—Carbon” play a crucial role in the carbon cycle and ecosystem health.
Something went wrong, please try again later.
This resource hasn't been reviewed yet
To ensure quality for our reviews, only customers who have purchased this resource can review it
Report this resourceto let us know if it violates our terms and conditions.
Our customer service team will review your report and will be in touch.